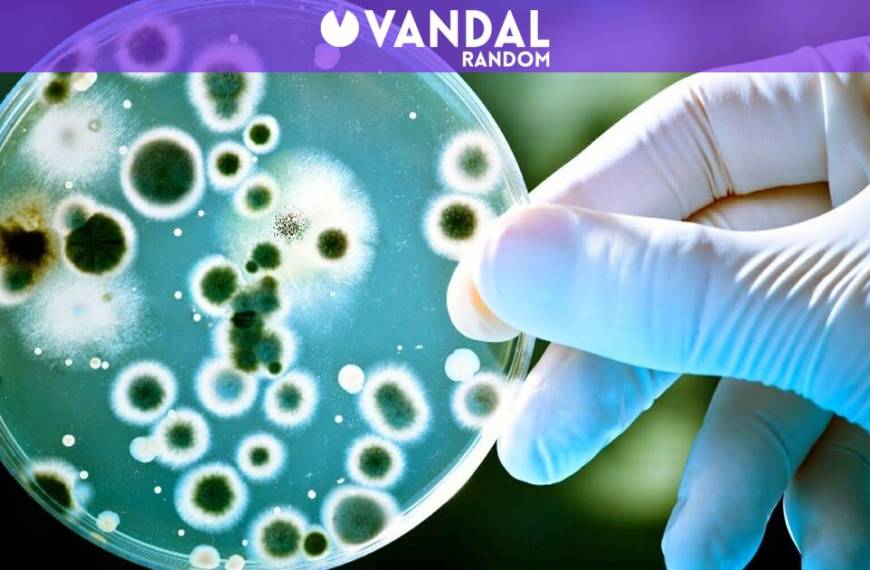
Bacterias Espejo: ¿Un Peligro Mortales para el Planeta?

En una emocionante jornada deportiva, la selección chilena Sub 17, dirigida por Ariel Leporati, ha tomado la delantera en su partido contra Bolivia en los playoffs del Sudamericano Sub 17, con vistas a asegurar un cupo para el Mundial de Qatar 2026. Desde el inicio del encuentro, La Roja ha demostrado su solidez y agresividad en el ataque, lo que le permitió construir una ventaja contundente que los pone en una buena posición para avanzar en el torneo. Los fanáticos chilenos ya están celebrando el triunfo parcial de 3-0, que podría catapultar a estos jóvenes talentos al escenario mundial del fútbol.
La primera mitad del juego fue frenética, con Chile abriendo el marcador a través de un error del arquero boliviano, Borda, que permitió que Amaro Riveros aproveche la oportunidad, marcando el 1-0 apenas en el minuto 32. Con este impulso, La Roja continuó dominando el juego, y justo antes del descanso, Joaquín Muñoz amplió la ventaja con un golpe de cabeza tras un tiro de esquina, dejando el marcador en 2-0 al final de los primeros 45 minutos. Los jugadores mostraron un gran nivel de cohesión y estrategia, clave para este momento decisivo del torneo.
En el segundo tiempo, la autoridad del combinado chileno se hizo aún más evidente. Baltazar Oróstica selló el resultado con un tercer gol a los 51 minutos, marcando el 3-0 que prácticamente asegura la clasificación de Chile al Mundial si el marcador se mantuviese. Cada jugada del equipo nacional se ejecuta con destreza, y la actuación estelar del arquero Vicente Villegas, que incluso detuvo un penal en el 55′, ha sido fundamental para mantener la ventaja y la moral alta entre los jugadores y los hinchas.
Los escenarios para Chile son claros: una victoria asegura el paso a la competición mundial de fútbol, mientras que un empate les llevaría a un angustiante desempate por penales. La presión está presente, pero los jóvenes chilenos han demostrado una madurez increíble en la cancha. A medida que avanza el partido, la posibilidad de cumplir el sueño mundialista sigue muy viva, y la afición en el estadio vibra con cada jugada. Este enfrentamiento contra Bolivia no solo es un partido, es una oportunidad para dejar una huella en el fútbol chileno.
Mientras la emoción se mantiene en el aire, los aficionados y críticos deportivos siguen de cerca cada instante de este apasionante encuentro. Ante el respaldo masivo de su hinchada y la determinación de los jugadores, Chile se posiciona como el favorito en esta etapa crucial del Sudamericano Sub 17. Este triunfo no solo sería una escalera hacia el Mundial, sino también un paso importante para la nueva generación del fútbol chileno, que busca demostrar su talento en la escena internacional.